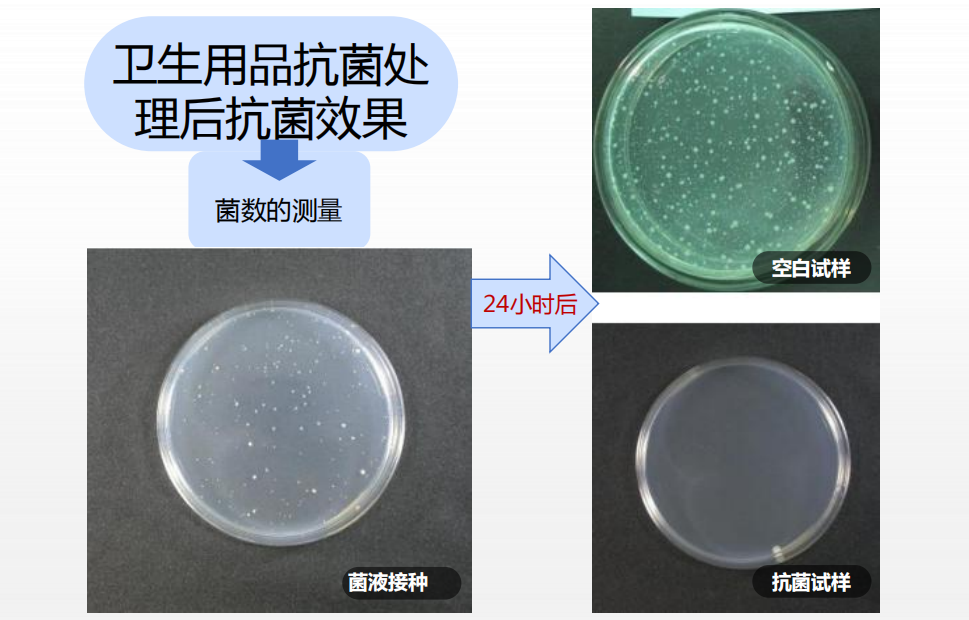
图片

合理使用抗菌材料,医疗抗菌大有作为?
2022-09-19 14:21阅读:
合理使用抗菌材料,医疗抗菌大有作为?
由于细菌用肉眼无法观察到,消费者难以用感官辨别抗菌材料的效果。很多人不禁怀疑,市面上的抗菌导尿管、抗菌敷料等产品到底靠不靠谱?今儿小编就和您一起来看看医疗抗菌材料。
世界卫生组织(WHO)颁布的《院内感染防治实用手册》中的数据显示,每天全世界有超过1400万人正在遭受院内感染的痛苦,其中60%
的细菌感染与使用的医疗器械有关。

常见院内感染(nosocomial infections)
医学发展到今天,医院、诊所等医疗环境感染仍然是所有医院的一大难题。
一、当前院内感染解决方案——抗生素。
为了应对医疗器械及植入物造成的感染,目前临床上多采用抗生素系统治疗——通过口服或注射等方式进行抗生素全身给药。
但是通过抗生素解决院内感染的方式具有明显的缺点:
1、经血液循环输送的药物在内植物周围组织往往
难以达到足够和有效抑菌浓度而无法发挥理想的治疗效果;
2、抗生素本身具有一定的副作用。
3、抗生素会产生过敏反应,并不是每一个人都适用。
4、抗生素会使细菌产生耐药性。

如果能从材料自身角度解决器械的细菌感染问题,减少因抗生素带给患者的副作用,达到对细菌感染的有效预防和治疗具有重要的临床意义。
纱布、消毒敷料、听诊器等医疗用品一般直接与皮肤和血液接触,其卫生安全要求相对较高。
在高致病环境里,有针对性地对相关医疗器械表面
添加抗菌技术,不但能够防止自身被致病细菌侵害,还能抑制接触表面的细菌繁殖,防止疾病传播,降低交叉感染率,保证人体的健康和安全。

因此,挑选合适的抗菌剂,对于医疗用品生产商们来说,至关重要。
季铵盐抗菌技术和材料是目前国际上公认为理想、安全环保的新型抗菌技术。接触式杀菌机理,使蛋白酶丧失活性,当细菌接触到抗菌物体表面,细菌就会被杀死,有极强的抗菌能力。
欧姆康科技深耕季铵盐抗菌剂8余年
欧姆康科技深耕季铵盐抗菌剂8余年,可以将季铵盐抗菌技术融入各类医疗产品,杀死其表面的致病细菌,比如大肠杆菌、金黄色葡萄球菌、白色念珠菌等,有效帮助提升医疗卫生用品的卫生程度。
欧姆康抗菌技术丨在医疗用品上的应用
在医用纱布上的应用
使用欧姆康季铵盐抗菌剂制成多种医用纱布、绷带、创可贴等,用于伤口治疗和创面愈合,避免创伤感染和发炎,在伤口愈合等方面应用广泛。
在医疗器械表面的应用
在医疗器械表面涂料添加欧姆康抗菌剂,对金黄色葡萄球菌、大肠杆菌、淋球菌、白色念珠菌、真菌、酵母菌等病原体微生物的生长有明显的抑制作用,为使用者打造一个隐形防护罩。
在医疗衣物及其他卫生用品的应用
手术无菌服、医务人员服饰、病床帘、妇婴卫生用品等加入相应欧姆康抗菌剂,可以有效解决人与人、人与物、物与物交叉感染,达到科学防预的目的。
在医疗器械伤口敷料上应用
将欧姆康抗菌剂应用于伤口敷料,可有效解决褥疮、糖尿病患者伤口、动静脉溃疡伤口、烧烫伤等因感染而导致延迟愈合伤口。
............
无论您是哪种类型的医疗用品生产商,
我们欧姆康科研团队能提供相对应的抗菌技术应用解决方案,,探讨更多合作细节,共推大健康产业发展。

最后小编认为,提高消费群体的抗菌意识,规范行业标准,促进抗菌产品的科学使用才能更好地让抗菌材料造福社会,让消费者的钱花得明明白白,物超所值~
